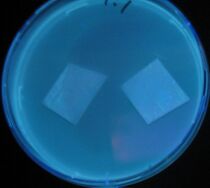
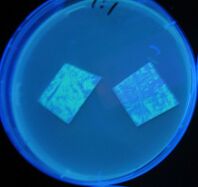
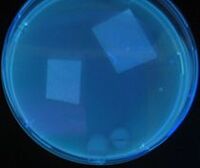
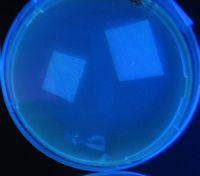
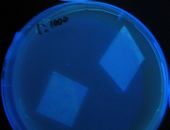

Team:Chiba/Demo experiments
<html><link rel="stylesheet" href="http://2008.igem.org/wiki/index.php?title=User:Maiko/chiba.css&action=raw&ctype=text/css" type="text/css" /></html>

| Home | The Team | The Project | Parts Submitted to the Registry | Reference | Notebook | Acknowledgements |
|---|
Demonstration Experiment ~Senders~
Method
- Pre-culture
- Picked and cultured the following glycerol stocks in 2mL of LB:
- LB-Amp, BBa_T9002, (JW1908)
- LB-Amp+0.2%Glu, BBa_K084012(plac+rbs+LuxI(no LVA)), (XL10G)
- LB-Amp+0.2%Glu, BBa_K084007(plac+rbs+LasI(no LVA)), (XL10G)
- Cultured at 37°C for 12h.
- Picked and cultured the following glycerol stocks in 2mL of LB:
- Culture
- Added 6.25% each of the pre-cultures to new LB medium.
- LB-Amp, BBa_T9002
- LB-Amp+0.2%Glu, BBa_K084012(plac+rbs+LuxI(no LVA)), BBa_K084007(plac+rbs+LasI(no LVA))
- Cultured at 37°C for 4~5h。
- Added 6.25% each of the pre-cultures to new LB medium.
- Wash
- Transfer 10mL each of the culture to 50mL centrifuge tubes.
- Centrifuged for 6min at 3600rpm,20°C and discarded the supernatant.
- Added LB-Amp to each centrifuge tube:
- 10mL to the tube that contains BBa_T9002
- 5mL to the tube that contains BBa_K084012, BBa_K084007
- Centrifuged for 6min, 3600rpm at 20°C the tube containing BBa_K084012, BBa_K084007 and discarded the supernatant.
- 10mL to the tube that contains BBa_K084012, BBa_K084007
- Centrifuged for 6min, 3600rpm at 20°C the tube containing BBa_K084012, BBa_K084007 and discarded the supernatant.
- 5mL to the tube that contains BBa_K084012, BBa_K084007
- Mix
- Mixed the sender cells BBa_K084012 and BBa_K084007 both with BBa_T9002 at a 1:1 ratio.
- Added 100μL each to a 96-well shallow plate (as shown in the figure).
- Green part is BBa_K084012:BBa_T9002=1:1
- Red part is BBa_K084007:BBa_T9002=1:1
- Uncolored part is BBa_T9002 alone.
- Culture and observe results
Results
 Green region: sender=LuxI,
Red circular region: sender=Las I.
Green region: sender=LuxI,
Red circular region: sender=Las I.
-
0 h
-
4 h
(Lux I GFP detected) -
8 h
(Lux I GFP and Las I GFP detected)
LuxI GFP is detected at 4h following mixing while LasI GFP is detected
after 8h, thus successfully demonstrating time-delay depending on the
sender used.
Demonstration Experiment ~Receivers~
Varying bacterial numbers: method
- Receiver(T9002) pre-incubation
- Sender(S03623) pre-incubation
- Sender:BBa_S03623(JW1908) was cultured in 50mL entrifuge tubes in 10mL of LB-Amp (37°C,12h)(2tubes)
- Sender Wash
- Centrifuged 2 tubes containing(BBa_T9002(JW1908))at 20°C,3600rpm for 6min and discarded supernatant.
- Added 10mL LB-Amp to each tube.
- Repeated wash twice.
- Creating bacterial plates
- LB-Amp pre-cultured Sender(BBa_S03623(JW1908)) tube 1 (10mL) was mixed with LB-Amp-agar(50°C)(10ml)to produce sender containing bacterialplate-1.
- LB-Amp pre-cultured Sender(BBa_S03623(JW1908)) tube 2(100μl)was mixed with LB-Amp(9.9ml) and diluted 100-fold. 10ml of this solution was mixed with LB-Amp-agar(50°C)(10ml) and created Sender(BBa_S03623(JW1908))containing bacterial plate-2.
- LB-Amp pre-cultured Sender solution-2(10μl) and LB-Amp(9.99ml)was mixed to dilute1000-fold.10ml of this solution and LB-Amp-agar(50°C)(10ml) was mixed to create Sender(BBa_S03623(JW1908) containing bacterial plate-3
- Lifted with nitrocellulose
- Receiver(BBa_T9002(JW1908))colony was transfered to a nitrocellulose filter and placed on each of Sender(BBa_S03623(JW1908))containing bacterial plate (1~3) and Sender-absent negative control plate (t=0). Determined the time required for the colonies to fluoresce depending on the bacterial concentration (100 and 1000-fold dilution).
- Method to detect fluorescence
- Plates cultured at 37°C were exposed to UV (312nm) light once every 30 minutes to observe GFP fluorescence.
Testing different receivers-methods
- Receiver&sender pre-culture
- Used Receivers were:
- BBa_T9002:ptet-luxR-plux-GFP(high copy)
- ptet-luxR-(low copy),BBa_J37032:plux-GFP(high copy)
- BBa_T9002:ptet-luxR-plux-GFP(low copy)
- ptet-mLuxR(too sensitive)-plux-GFP
- ptet-luxR-plux-GFP-plac-aiiA
- (all JW1908)Each was cultured in 2ml LB (37°C,12h) and plated so that about 1000 colonies of receiver cells will grow.
- Sender:BBa_S03623(JW1908) was cultured in 10mL LB in 50mL centrifuge tubes (37°C,12h)
- Used Receivers were:
- sender wash
- Each receiver-containing medium was centrifuged in 50mL tubes at de20°C, 3600rpm for 6min and supernatant discarded.
- Added 10mL LB to each tube.
- Repeated wash twice.
- Creating bacterial plates
- LB pre-cultured Sender(BBa_S03623(JW1908)) tube 1 (10mL) was mixed with LB-agar(50°C)(10ml)to produce sender containing bacterial plate-1.
- LB pre-cultured Sender(BBa_S03623(JW1908)) tube 2(100μl)was mixed with LB(9.9ml) and diluted 100-fold. 10ml of this solution was mixed with LB-agar(50°C)(10ml) and created Sender(BBa_S03623(JW1908)) containing bacterial plate-2.
- LB pre-cultured Sender solution-2(10μl) and LB(9.99ml) was mixed to dilute 1000-fold.10ml of this solution and LB-agar(50°C)(10ml) was mixed to create Sender(BBa_S03623(JW1908)) containing bacterial plate-3
- Lifted with nitrocellulose
- Each Receiver colony was transfered to a nitrocellulose filter and placed on a Sender(BBa_S03623(JW1908)) containing bacterial plate (1~3) or a sender-absent negative control plate(t=0) to observe how receiver type affects the time taken for the colonies to display visible fluorescence.
- Method to detect fluorescence
- Plates cultured at 37°C were exposed to UV (312nm) light once every 30 minutes to observe GFP fluorescence.
Varying bacterial numbers-results and discussion
results
0h 0.5h 1.0h
100-fold dilution
0h 0.5h 1.0h 1.5h
1000-fold dilution
0h 0.5h 1.0h 1.5h 2.0h
discussion
We demonstrated that the GFP expression switch is delayed by the ratio of sender to receiver. The result indicates that the amount of AHL from one bacterium per time is constant and independent of bacteria number density. This is probaly because the sender has no feedback circuit of AHL production. Although this strategy can not change the time interval, we can manage the switch timing by changing the ratio of sender to receiver.
Testing different receivers-results and discussion
results
0h 0.5h 1.0h 1.5h
1=N.C
2=BBa_T9002:ptet-luxR-plux-GFP(high copy)
3=ptet-luxR-(low copy),BBa_J37032:plux-GFP(high copy)
4=BBa_T9002:ptet-luxR-plux-GFP(low copy)
5=ptet-mLuxR(too sensitive)-plux-GFP
6=N.C
7=ptet-luxR-plux-GFP-plac-aiiA
discussion
- Number 2,3 and 5 fluoresces in 30 min. We could not see time difference of these, it may be resulted from excess amount of sender bacteria.
- Precise experiments controlling the number of sender are necessary for further discussion.
- In comparizon with number 2 (T9002:high copy), there was no change of fluorescence intensity of number 4 (T9002:low copy) in 4 hours.
- It is probably because of circuit working, since the AHL is provided enough for the receiver.
Demo Experiment ~Temporal imaging system~
Method
- Receiver(T9002)
- Receiver:BBa_T9002, T9002-p15A and AiiA Receiver (JW1908) was cultured in 2mL LB-Amp-Cm, respectively. (37°C,12h)
- Pre-incubated Receivers was spotted so as to produce about 300 colonies on a nitrocellulose Filtter.
- Incubated 37°C,12h.
- Sender(S03623)
- Sender:BBa_S03623(JW1908) was cultured in 10mL of LB-Amp-Cm (37°C,12h) and after 12 h, added 10ml of LB Ager-Amp-Cm into the incubated Sender.
- Lifted Receiver colony with nitrocellulose Filter to the bacterial plate.
- Cultured at 37°C, 12h.
- Exposed to UV (312nm) light once every 30 minutes to observe GFP fluorescence.
Result

Leaves, a stem and a flower was drawned with BBa_T9002, T9002-p15A, and AiiA Receiver, respectively on the plate containing BBa_S03623 (AHL sender)
Discussion
GFP coloration of AiiA Receiver(flower blossom) wasn't observed.
We will try again with different method or in different condition until recognizing that the flower grow up!
| Home | The Team | The Project | Parts Submitted to the Registry | Reference | Notebook | Acknowledgements |
|---|